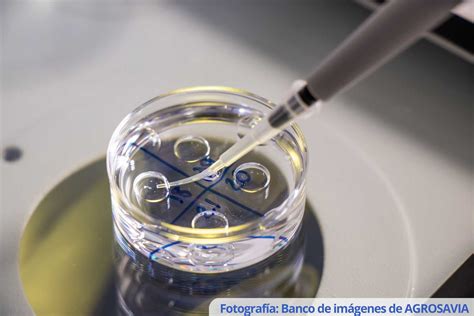
Embriones en cultivo en laboratorio

La Transferencia Embrionaria: Un Momento Crucial en la Reproducción Asistida
La transferencia embrionaria se erige como uno de los momentos culminantes en cualquier tratamiento de reproducción asistida, al igual que el instante en que se realiza la prueba de embarazo. Tras la punción folicular y la fecundación del ovocito en el laboratorio, el embrión inicia su desarrollo, quedando pendiente su traslado al útero materno. Este traslado puede efectuarse en el día 2-3 o en el día 5-6 post-punción, y la elección del momento óptimo depende de diversos factores.
Según la Dra. Clara Colomé, especialista en reproducción asistida, en un embarazo natural, el embrión alcanza el útero y se implanta en el endometrio aproximadamente entre el día 5 y 6 de vida. Sin embargo, en el laboratorio de reproducción asistida, la evolución del embrión en la incubadora durante los días 3 a 5 es un periodo más delicado, ya que el embrión transita de ser un organismo de 4-8 células a un blastocisto con cientos de células. Por esta razón, la mayoría de las transferencias se realizan en los días 2-3 tras la punción, un momento en el que el embrión se encuentra en una fase de desarrollo que permite al laboratorio asegurar las condiciones necesarias para su correcto crecimiento.
Transferencia en Día 5: Una Opción Estratégica
En ciertas circunstancias, se considera la opción de realizar la transferencia en el día 5, cuando el embrión ya ha alcanzado el estadio de blastocisto. Esta alternativa se valora especialmente en pacientes que han experimentado varios fallos de implantación tras múltiples fecundaciones in vitro con transferencia en día 2-3. Asimismo, la transferencia en día 5 se tiene en cuenta en mujeres que recibirán un único embrión, con el fin de evitar embarazos gemelares, ya sea por deseo expreso o por indicación médica, como en casos de diabetes o hipertensión.
La decisión sobre el día más adecuado para la transferencia embrionaria se toma considerando las circunstancias particulares de cada paciente. En ocasiones, la decisión puede ser modificada por el embriólogo al observar los embriones. Por ejemplo, si estaba prevista una transferencia en día 3, pero el embriólogo considera que, por el número y desarrollo de los embriones, es preferible posponer la transferencia para realizar una mejor selección.
El Cultivo a Blastocisto: Maximizando el Potencial de Implantación
Los laboratorios de Fecundación In Vitro (FIV) modernos, equipados con tecnología avanzada en incubadoras, medios de cultivo, control de calidad y profesionales cualificados, permiten que todas las transferencias se realicen en estadio de blastocisto, es decir, cuando el embrión tiene 5 o 6 días de vida. Los blastocistos de buena calidad, en los que el genoma embrionario ya se ha activado, presentan un potencial de implantación muy elevado.
El desarrollo del embrión hasta blastocisto implica la formación de la masa celular interna (que dará lugar al feto) y el trofoectodermo (que formará la placenta). Este proceso de diferenciación ocurre entre el día 4 y 5. Al valorar los embriones en el día 5, lo ideal es observar un blastocisto ya cavitado y con sus estructuras definidas. Durante los días 5 y 6, el blastocisto continúa creciendo hasta abandonar la zona pelúcida que lo protege, preparándose para implantar en el útero por contacto directo de las células del trofoectodermo con las células endometriales.
En casos donde los blastocistos se desarrollan más lentamente, pudiendo observarse mórulas o blastocistos muy tempranos en el día 5, los embriones pueden dejarse en cultivo hasta el día 6 para valorar si se han formado las estructuras propias del blastocisto. Si es así, se procede a la transferencia en día 6.

El Proceso de FIV: De la Estimulación a la Transferencia
El proceso de FIV (fertilización in vitro) es un camino con pasos claros, aunque su ritmo puede variar ligeramente en cada caso. Generalmente, un ciclo de FIV dura entre 4 y 6 semanas, desde el inicio de la estimulación ovárica hasta la transferencia del embrión.
Consulta Inicial y Pruebas de Fertilidad
Antes de comenzar con la FIV, se realiza una consulta inicial con un especialista en fertilidad. Esta etapa incluye pruebas de fertilidad, como análisis hormonales, ecografías y análisis de semen, para determinar el mejor plan de tratamiento.
Estimulación Ovárica
Durante esta fase, la paciente recibe medicamentos inyectables (gonadotropinas) para estimular los ovarios a producir múltiples óvulos. El objetivo es maximizar las posibilidades de fecundación y embarazo. Algunas pacientes pueden necesitar medicamentos previos, como píldoras anticonceptivas, para coordinar el crecimiento folicular y mejorar la obtención de óvulos maduros.
La estimulación ovárica con hormona folículoestimulante (FSH) y, en algunos casos, hormona luteinizante (LH), suele durar entre ocho y diez días. El seguimiento se realiza mediante análisis de sangre y ecografías vaginales para evaluar el crecimiento folicular. Se administran también medicamentos para prevenir la ovulación prematura, como Lupron o Cetrotide.
Extracción de Óvulos (Ovum Pick-Up)
La extracción de óvulos es un procedimiento ambulatorio en el que se recogen óvulos maduros de los ovarios. Se realiza bajo sedación ligera o anestesia para garantizar la comodidad de la paciente y suele durar menos de una hora. Mediante una sonda vaginal guiada por ultrasonido, se aspiran los folículos ováricos.
Fecundación en Laboratorio
Los óvulos extraídos se fertilizan con esperma en el laboratorio. Existen dos técnicas principales: la FIV convencional, donde óvulos y espermatozoides se colocan juntos, y la inyección intracitoplasmática de espermatozoides (ICSI), donde un solo espermatozoide se inyecta directamente en cada óvulo. La ICSI se recomienda en casos de problemas de fertilidad masculina o fallos de fecundación previos.
Los embriólogos supervisan cuidadosamente cada óvulo en busca de signos de fecundación y desarrollo temprano, asegurando el mejor entorno posible para el crecimiento embrionario.
Cultivo Embrionario
Tras la fecundación, los embriones entran en la fase de cultivo, desarrollándose en un entorno de laboratorio controlado durante varios días. Tradicionalmente, los embriones se cultivaban hasta el tercer día; sin embargo, con los avances tecnológicos, el cultivo hasta el quinto día (blastocisto) es cada vez más común.
Durante el cultivo, los embriones son monitorizados de cerca. La mayoría de los centros recetan estrógeno y progesterona después de la extracción de óvulos para preparar el revestimiento uterino para la implantación.
Preparación Endometrial
Para que la implantación sea exitosa, el endometrio (revestimiento del útero) debe estar receptivo. Esto se logra mediante la administración de hormonas, ya sea en un ciclo natural monitorizado o en un ciclo controlado con estrógenos y progesterona. El Test ERA (Endometrial Receptivity Analysis) puede utilizarse para determinar el momento óptimo de la ventana de implantación.
Transferencia Embrionaria (TE)
La transferencia de embriones es el siguiente hito. El procedimiento es breve, generalmente indoloro y se realiza con delicada precisión. Utilizando una guía ecográfica, el ginecólogo introduce un catéter delgado a través del cuello uterino hasta el útero para depositar los embriones seleccionados. La transferencia se realiza a menudo con la vejiga llena para facilitar la visualización y el acceso al útero.
En España, la legislación permite transferir hasta tres embriones, aunque la tendencia actual es la transferencia única de un embrión, especialmente en estadio de blastocisto, para minimizar el riesgo de embarazos múltiples.

Seguimiento Post-Transferencia y Betaespera
Tras la transferencia embrionaria, comienza el periodo conocido como "betaespera", un tiempo de anticipación hasta la prueba de embarazo. Durante este periodo, la mayoría de las pacientes continúan con la medicación hormonal para favorecer el revestimiento uterino y mantener un posible embarazo.
Emocionalmente, esta fase puede ser estresante. Se recomienda seguir las indicaciones médicas, evitar el estrés innecesario y centrarse en el autocuidado. Aproximadamente diez a catorce días después de la transferencia, se realiza un análisis de sangre para medir los niveles de la hormona beta-hCG y confirmar el embarazo.
El proceso completo de FIV, desde la estimulación ovárica hasta la transferencia, suele durar entre cuatro y seis semanas. Las molestias físicas suelen ser mínimas, aunque los altibajos emocionales pueden ser más desafiantes. En la mayoría de los casos, las pacientes pueden retomar sus actividades normales poco después de la transferencia, evitando esfuerzos físicos intensos durante un breve periodo.
Consideraciones Adicionales y Preguntas Frecuentes
¿Cuándo se considera la transferencia en día 6?
Aunque no es lo más habitual, la transferencia en día 6 puede realizarse si el desarrollo embrionario es más lento de lo normal y se necesita un día adicional para valorar la calidad de los blastocistos.
¿Es recomendable la transferencia de dos embriones en día 3?
La decisión de transferir dos embriones depende de la situación individual de cada paciente. Sin embargo, la tendencia actual se inclina hacia la transferencia de un único embrión en estadio de blastocisto debido a sus ventajas.
¿Se puede realizar la transferencia embrionaria en día 4?
No es recomendable. En día 4, el embrión se encuentra en estadio de mórula, y su calidad es difícil de determinar con precisión.
¿Qué sucede si un embrión se queda adherido a la cánula de transferencia?
Esto puede ocurrir, pero generalmente no disminuye la calidad del embrión ni la tasa de implantación. Los embriólogos revisan las cánulas para asegurar la correcta transferencia.
¿Es recomendable hacer un control analítico y ecográfico el día previo a la transferencia?
Sí, es habitual realizar un control ecográfico y analítico de los niveles de progesterona el día anterior a la transferencia embrionaria.
Abortos de repetición y día de transferencia
Los abortos de repetición no están directamente relacionados con el día de la transferencia, sino más bien con la dotación cromosómica de los embriones. En estos casos, la Fecundación In Vitro con Diagnóstico Genético Preimplantacional (DGP) es un tratamiento idóneo.
Transferencia en día 3 con DGP
Actualmente, la mayoría de las biopsias para DGP se realizan en día 5, haciendo imposible la transferencia en día 3. Si la biopsia se realiza en día 3, el resultado se obtiene el día 5, y los embriones se transfieren en estadio de blastocisto.
¿Se consiguen embarazos con embriones en día 3?
Sí, es posible lograr un embarazo transfiriendo embriones en día 3, aunque la tendencia actual favorece la transferencia en estadio de blastocisto.
Transferencia del embrión en día 3 o día 5. Ventajas e inconvenientes
tags: #procedimiento #de #laboratorio #en #dia #5